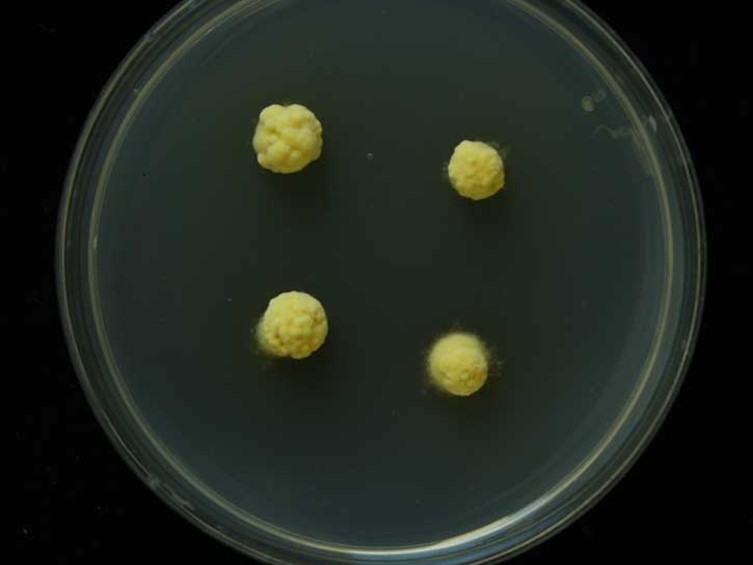

Holotype:
THAILAND, Chanthaburi Province, Khao Soi Dao Wildlife Sanctuary, 1 May 2007, W. Chaygate, S. Mongkolsamrit, R. Ridkaew, K. Tasanathai, B. Tongnuch, holotype BBH 22536, ex-type living culture BCC 30560.
Habitat:
Underside of dicotyledonous leaves.
Host:
Scale insect nymphs (Hemiptera).
Description:
 Sexual morph: stroma pulvinate, up to 3.5 mm diam, ca 2 mm high, moderately hard, yellow-brown to orange-brown, internally brown.
Sexual morph: stroma pulvinate, up to 3.5 mm diam, ca 2 mm high, moderately hard, yellow-brown to orange-brown, internally brown.  Perithecia scattered, embedded in stroma, flask-shaped, 120-180 μm high, up to 80 μm wide.
Perithecia scattered, embedded in stroma, flask-shaped, 120-180 μm high, up to 80 μm wide.  Asci 8-spored, up to 80 μm long, 5 μm wide.
Asci 8-spored, up to 80 μm long, 5 μm wide.  Ascospores 30-40 μm × 1.0-1.5 mm, blunt at distal end, tardily fragmenting into four parts.
Ascospores 30-40 μm × 1.0-1.5 mm, blunt at distal end, tardily fragmenting into four parts.  Asexual morph: stroma pulvinate.
Asexual morph: stroma pulvinate.  Conidiomata pycnidial, irregular with creamorange conidial mass.
Conidiomata pycnidial, irregular with creamorange conidial mass.  Conidiogenous cells phialidic, cylindrical, up to 30 μm long.
Conidiogenous cells phialidic, cylindrical, up to 30 μm long.  Paraphyses present, linear, filiform, flexuous, up to 125 μm long, 1.2-2.0 μm wide.
Paraphyses present, linear, filiform, flexuous, up to 125 μm long, 1.2-2.0 μm wide.  Conidia allantoid, with rounded ends 5-7 μm long, 1.2-2.0 μm wide.
Conidia allantoid, with rounded ends 5-7 μm long, 1.2-2.0 μm wide.
Culture characteristics:
Colonies on PDA slow-growing, ca 5 mm diam after 8 wk. Stromatic colonies pale yellow, forming compact mycelium. Conidia pale cream-orange masses produced on margin of stromatic colonies after ca 8 wk.
Colonies on PDA slow-growing, ca 5 mm diam after 8 wk. Stromatic colonies pale yellow, forming compact mycelium. Conidia pale cream-orange masses produced on margin of stromatic colonies after ca 8 wk.
Reference:
Mongkolsamrit S, Luangsa-Ard JJ, Hywel-Jones NL. (2011). Samuelsia mundiveteris sp. nov. from Thailand. Mycologia 103: 921–927.
DOI: https://doi.org/10.3852/11-049Species |
Strain |
Compound |
Pubchem CID |
Biological activity |
Reference |
|---|
|
Strain |
LSU | TEF1 |
|---|---|---|
| BCC 30560 | GU552156 | GU552141 |
| BCC 31750 | GU552157 | GU552142 |
| BCC 40021 | GU552152 | GU552145 |
| BCC 40022 | GU552153 | GU552146 |